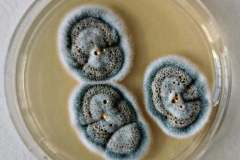
241132877_604566783875077_881202489904510211_n
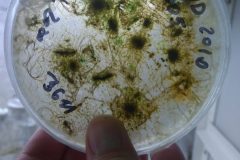
Na-labakoch-51-scaled

Oddelenie biológie na Dni otvorených dverí (DOD) 2024
no images were found
Workshopy pre stredné školy na Oddelení biológie
Oddelenie biológie na DOD 2018
Klub VšeVed – ako sme začali a čo všetko sme spolu zažili
Na labákoch
V teréne a v praxi
no images were found
Na cestách a výletoch
no images were found
Konferencia Biologické a medicínske vedy, Niğde, Turecko, 2018
no images were found
Erasmus – zahraničná stáž, Polytechnická univerzita vo Valencii, Španielsko, 2018
Grilovačky, Haluškovanie
Oddelenie biológie na športovom dni 2018
no images were found
Konferencia Aplikované prírodné vedy (ANS) 2019
no images were found
Konferencia Európsky fykologický kongres, Zahreb, Chorvátsko 2019
no images were found